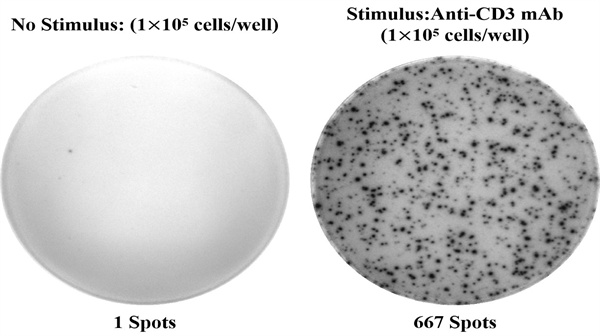
新闻图片1

超灵敏检测!Elabscience 人IL-4(白介素4)ELISPOT试剂盒助力免疫研究突破
275 人阅读发布时间:2025-07-08 11:55
Elabscience 自主研发的人白介素 4(IL-4)酶联免疫斑点检测试剂盒(货号 ESP-H0007),凭借百万分之一的超高灵敏度,实现单细胞水平的免疫功能动态检测,精准量化分泌 IL-4 的细胞频率,为免疫研究提供可靠工具。
- 核心信息:该试剂盒中文名称为人白介素 4(IL-4)酶联免疫斑点检测试剂盒,对应英文名称为 Human IL-4 (Interleukin 4) ELISPOT Kit,货号为 ESP-H0007。
- 规格与价格:提供 96T 和 96T×5 两种规格,价格分别为 3000 元与 12500 元。
- 基本特性:反应时间仅需 3 小时 30 分钟,样本体积为 100μL,适用于悬浮细胞检测,且仅对人样本有反应性,储存于 2-8℃条件下,有效期 12 个月。
人IL-4(白介素4)ELISPOT试剂盒是基于双抗夹心法原理,用抗人IL-4抗体包被于微孔板底部PVDF膜上,实验时加入细胞悬液和刺激剂,细胞在培养过程中分泌的人IL-4会与包被抗体结合。通过洗涤除去细胞和未结合的物质,依次加入生物素化的抗人IL-4抗体和碱性磷酸酶标记的亲和素。生物素化的抗人IL-4抗体与结合在包被抗体上的人IL-4结合、生物素与亲和素特异性结合而形成免疫复合物,游离的成分被洗去。加入显色底物(BCIP/NBT),BCIP在碱性磷酸酶的催化下水解并与NBT发生反应,形成不溶性的深蓝色至蓝紫色斑点。用专业的ELISPOT读板仪软件分析,计算分泌人IL-4的细胞频率。
Elabscience 人 IL-4 酶联免疫斑点检测试剂盒凭借对分泌 IL-4 细胞频率的精准捕捉能力,在多个研究领域发挥关键作用:
- 免疫学基础研究:作为解析 Th2 型免疫应答机制的核心工具,可直接量化 IL-4 分泌细胞的动态变化,助力探索免疫细胞分化、细胞因子网络调控等基础科学问题,例如研究 T 细胞亚群功能失衡与免疫稳态的关联。
- 疫苗研发与评估:在疫苗免疫原性评价中,通过检测接种后机体分泌 IL-4 的细胞频率,直观反映疫苗诱导的特异性体液免疫应答强度,为疫苗效力验证和优化提供量化依据。
- 自身免疫性疾病研究:针对哮喘、过敏性鼻炎等与 IL-4 过表达相关的疾病,可通过分析患者样本中 IL-4 分泌细胞的分布特征,揭示疾病发病机制,为潜在治疗靶点的发现提供数据支撑。
- 肿瘤免疫研究:在肿瘤微环境分析中,监测 IL-4 分泌细胞的浸润情况,探究其在肿瘤免疫逃逸或免疫激活中的作用,为免疫疗法的开发提供参考。
- 感染性疾病研究:用于评估机体在病毒、细菌等病原体感染后,IL-4 介导的免疫防御反应强度,辅助解析抗感染免疫的调控机制。
该试剂盒以高特异性和单细胞水平检测优势,为上述领域的机制研究、药物筛选及疗效评估提供可靠的实验数据,是免疫功能研究中不可或缺的高效工具。
- 超高灵敏度:达到百万分之一,能够精准捕捉低频率分泌 IL-4 的细胞。
- 单细胞水平检测:实现对单个细胞分泌功能的分析,深入了解细胞异质性。
- 动态免疫功能性检测:可实时监测免疫细胞在不同条件下的功能变化。
- 结果直观可信:通过斑点直接呈现检测结果,易于观察和分析,且板内、板间变异系数均 < 10%,精密度高。
- 特异性强:可特异性检测样本中的人 IL-4,与其他类似物无明显交叉反应。
Elabscience 人 IL-4 酶联免疫斑点检测试剂盒以其超敏特性、精准检测能力和广泛的应用前景,成为免疫研究领域的得力助手。无论是基础研究还是临床前研究,都能为科研人员提供可靠、高效的检测支持,助力在免疫相关研究中取得更多突破性成果,赶紧入手体验吧!